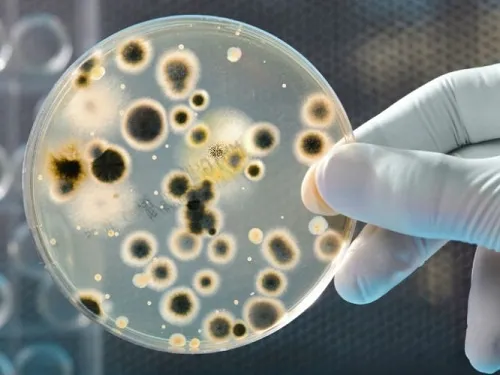

Quitarse los zapatos antes de entrar a casa no está tan mal

Quitarse los zapatos al entrar a la casa es una costumbre japonesa que, actualmente, miles de personas la han adoptado por comodidad y salud. La medida parece ser un poco rara y exagerada. Sin embargo, está demostrado que podría tener muchos beneficios para quienes la practican.
¿Alguna vez te has puesto a pensar en todos los escenarios que atraviesan tus zapatos durante un día entero? Seguramente, si lo haces, vas a encontrar varias razones para preocuparte pues, aunque lo ignoramos, el calzado adquiere día a día miles de bacterias y microorganismos.
Estos, a su vez, pueden causar potenciales enfermedades cuando el sistema inmunitario está débil, por ejemplo. En esta ocasión, queremos repasar un estudio científico que explica por qué es más conveniente liberarse de ellos justo en la entrada de la casa.
¿Quitarse los zapatos en la entrada de la casa?

Esta tradición japonesa de quitarse los zapatos antes de entrar a la casa ya está cobrando importancia en muchos otros lugares del mundo. Consiste en descalzarse justo después de llegar de la calle, bien sea colocando los zapatos en un casillero especial al lado de la puerta o un espacio destinado para estos.
En la cultura del país asiático se práctica por cuestiones de higiene y como un signo de respeto por el espacio privado. De hecho, la medida también se lleva a cabo en restaurantes, gimnasios y colegios. Distintos lugares frecuentados por los japoneses tienen esta medida sanitaria.
Esto ocurre porque el calzado es una de las principales vías de suciedad y contaminación en el hogar. Por el simple hecho de estar expuestos a muchas superficies en el ambiente ya es así.
Hoy en día algunos expertos han querido indagar en el tema y, efectivamente, han podido comprobar que estos son una fuente común de peligrosos patógenos.
Lee: Estos son los 5 problemas que llegan al hogar a través de los zapatos
Los zapatos tienen más bacterias que un inodoro
En el año 2012, una curiosa investigación empírica publicada en el Journal of Research in Personality comprobó que los zapatos pueden ser una buena fuente de información sobre la personalidad de los individuos.
Estos pueden reflejar una edad promedio, el sexo, la condición económica e, incluso, algunos rasgos psicológicos. Lo que no sabíamos hasta ahora es que estos accesorios son una gran fuente de bacterias. Incluso superan las que contiene un inodoro.
En un estudio liderado por Charles Gerba, profesor de microbiología de la Universidad de Arizona se demostró que, en apenas dos semanas de uso, unos zapatos alcanzan a acumular cerca de 42 0000 bacterias en su parte exterior. De estas, un 96 % son coliformes.
Con base en este estudio, un 27 % de las bacterias identificadas en los zapatos eran de la especie E. coli. Estos son microorganismos que habitan en el intestino de los humanos y los animales.
El experto sugiere que puede deberse al contacto frecuente que tiene el calzado con la materia fecal en la calle y en algunos de los suelos de los aseos públicos.

Si bien la mayoría de las E. coli no provocan problemas de salud, en algunos casos son las desencadenantes de enfermedades y episodios de diarrea crónicos.
Lo peor es que ahí no acaba todo. Entre los miles de microorganismos encontrados en las zapatillas, también se hallaron cantidades importantes de:
- Klebsiella pneumoniae, una de las responsables de las infecciones en el sistema urinario y neumonía, así como también de otras enfermedades de los tejidos blandos y heridas abiertas.
- Serratia marcescens, que suele ocasionar conjuntivitis, queratitis y, en casos reducidos, meningitis y endocarditis.
Ambas variedades de bacterias son las que atacan el organismo cuando este no tiene suficientes anticuerpos para defenderse. De hecho, son las que causan complicaciones dentro de los procedimientos realizados en los hospitales.
Descubre: Cómo luchar contra la bacteria que causa ardor, diarrea e hinchazón
Un buen hábito para poner en práctica
Es importante aclarar que las probabilidades de infección por bacterias provenientes de los zapatos son mínimas, a menos que por alguna razón estos tengan contacto directo con la boca o alguna herida abierta.
Hay que tener en cuenta que son muchos los medios que llevan las bacterias hasta el hogar. Por ende, el organismo se ha hecho fuerte para combatirlas.
Pese a esto, es conveniente evitar riesgos adoptando medidas simples como la de quitarse los zapatos antes de entrar al hogar. O bien, lavar los zapatos de manera constante con agua y jabón.
Todas las fuentes citadas fueron revisadas a profundidad por nuestro equipo, para asegurar su calidad, confiabilidad, vigencia y validez. La bibliografía de este artículo fue considerada confiable y de precisión académica o científica.
- Gillath, O., Bahns, A. J., Ge, F., & Crandall, C. S. (2012). Shoes as a source of first impressions. Journal of Research in Personality, 46(4), 423-430. https://www.sciencedirect.com/science/article/abs/pii/S0092656612000608
- CIRI Staff. Study Reveals High Bacteria Levels on Footwear. https://www.ciriscience.org/a_96-Study-Reveals-High-Bacteria-Levels-on-Footwear
- SHOE STUDY. Charles Gerba Sheri Maxwell. (2008). CFUs of Bacteria Shoe transfer rates.
Este texto se ofrece únicamente con propósitos informativos y no reemplaza la consulta con un profesional. Ante dudas, consulta a tu especialista.







